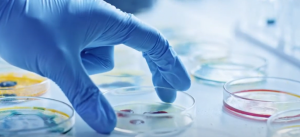
Biotehnologia: arma supremă pentru sănătatea umană și planetară

Răzvan Savaliuc: „Dacă soluția Sistemului pentru Președinția României va fi Nicolae Ciucă, înseamnă că ne ducem pe copcă”


- „De la începutul lui ianuarie intră în pâine noul CSM. Nu mă aștept la nimic bun, după schimbarea legilor Justiției”
- „Justiția este formată din magistrații profesioniști și din generația mai tânără, mai slab pregătită profesional. Generația tânără va începe să aplice comandamentele de la Bruxelles, în defavoarea Constituției”
- „Este foarte trist că oameni care au jurat pe Constituție au acceptat să renunțe la supremația Constituției. Toți au acționat la niște ordine politice subterane”
- „Cred că vor avea o nouă tentativă pe legile securității naționale. Daniel Morar s-a opus constant legilor Big Brother, nu mai văd cine ar putea face asta în CCR”
- „La ÎCCJ, cam toți șefii și-au tras abilitatea de a emite ei mandate de siguranță națională. Poziția unui judecător este incompatibilă cu cea a unui ofițer de informații”
- „Magistrații se gândesc că mai bine ies acum la pensie, își păstrează banii, cam 5000 de euro pe lună”
- „Este clar că este un comandament ca să nu se mai discute despre Justiție”
- „Nu mai există politicieni, toți sunt puși de servicii. Ce alegeri avem? Cele pe care le manipulează ei? Se vede ce fac serviciile: România s-a dus în gard”
- „România a fost ținută sub anatema țării corupte. Acum suntem sub o corupție internațională uriașă. Politicienii români dau totul pe tavă. Nu știam ce să mai dăm ca să fim primiți în Schengen”
- „Cea mai mare corupție în România este evaziunea fiscală pe care o fac marile companii. Firmele românești sunt călcate în picioare. La firmele mari se duce cineva? Vezi DNA cu un dosar de corupție pe marile companii? DNA nu acționează unde trebuie”
- „Bode să se ducă să învețe o limbă străină. Cum să intri în Schengen cu un ministru care nu știe o boabă de limbă străină?”
- „Nu cred că se va face rocada. PSD-ului i se va pregăti o nefăcută. Se va găsi o soluție minoritară tot cu PNL la guvernare”
- „Eșecul Schengen ar trebui să-l deconteze Președintele României. Proiectele lui Iohannis au fost România Educată și intrarea în Schengen”
- „Nu cred că Austria a luat decizia de capul ei. Nu cred că se putea opune fără Germania”
- „România din păcate n-are lideri iar serviciile nu par să lucreze pentru interesul național”
„De la începutul lui ianuarie intră în pâine noul CSM. Nu mă aștept la nimic bun, după schimbarea legilor Justiției. Cred că vom asista la un arbitrariu. Justiția este formată din magistrații profesioniști și din generația mai tânără, mai slab pregătită profesional. Unii magistrați tineri au făcut școala ca gâsca prin apă, dau soluții după stări emoționale. Ne trezim cu hotărâri judecătorești absolut strâmbe, pe care nu poți să le mai modifici. (…) Premierul Ciucă este peste Predoiu. Dacă îi iei foaia din față, nu mai știe să spună speechul. Ciucă este o catastrofă pentru România. Este foarte trist că oameni care au jurat pe Constituție au acceptat asta. Toți au acționat la niște ordine politice subterane. Probabil că au venit niște șefi de la SRI și le-au spus ce să facă, le-au spus să lase garda jos că intrăm în Schengen. Mulți dintre ei probabil se simt acum păcăliți. Au făcut prostia asta și, uite, n-am fost primiți în Schengen. Nu te poți opune Sistemului în funcțiile acestea: ori pleci, ori stai. Cei din CSM visează o altă funcție, nu vor să se întoarcă la dosare, vor sinecuri. Dacă sunt cuminți, li se promite câte un post. toți au cedat. Generația tânără va începe să aplice comandamentele de la Bruxelles, în defavoarea Constituției”, a declarat
în emisiunea OFF/OnTheRecord, pe Aleph News, Răzvan Savaliuc, senior editor la Lumea Justiției.
Răzvan Savaliuc a analizat în emisiunea OFF/OnTheRecord și cum arată CCR după schimbarea a trei judecători în 2022:
„Pe vremea lui Adrian Năstase, era ordine, nimeni nu trebuia să deschidă gura. Adrian Năstase stătea drepți, era bine relaționat internațional, nu pupa pe alții în fund. CCR va fi supusă în 2023, nu va fi CCR de până acum. Oamenii care au apărat Constituția au fost Daniel Morar și Mona Pivniceru. Tot ce vor dori cei de afară, CCR va face să se poată și constituțional. Da, cred că vor avea o nouă tentativă pe legile securității naționale. Daniel Morar s-a opus constant legilor Big Brother, nu mai văd cine ar putea face asta în CCR. Șefii SRI sunt peste tot în public. Cartea lui Daniel Morar ar trebui să fie un motiv de deschidere a unui dosar penal, dar nu se va întâmpla nimic. Hellvig a semnat protocol în Justiție în 2016. SRI a renunțat la interceptările ilegale? Cât timp lucrezi cu judecători care au numele șters pe mandatele de siguranță națională, nu e nicio șansă. Nu pot înțelege ce s-a întâmplat cu Corina Corbu, șefa ÎCCJ. ÎCCJ a simulat un control pe mandatele de siguranță națională. La ÎCCJ, cam toți șefii și-au tras abilitatea de a emite ei mandate de siguranță națională. Poziția unui judecător este incompatibilă cu cea a unui ofițer de informații. Nu mai există politicieni, toți sunt puși de servicii. Ce alegeri avem? Cele pe care le manipulează ei? O să li se dea și mai multă mână liberă celor din serviciile de informații. Se vede ce fac serviciile: România s-a dus în gard. România a fost ținută sub anatema țării corupte. Acum suntem sub o corupție internațională uriașă. Politicienii români dau totul pe tavă. Nu știam ce să mai dăm ca să fim primiți în Schengen. Nu este mai periculoasă corupția importată din UE? S-a văzut cu Schengen-ul: nimeni nu dă doi bani pe noi. Cum să ne primească pe noi în Schengen când ei realizează că dăm orice de pe masă? Avem liderii politici pe care-i merităm. Nu-i mai alegem noi”.
Senior editorul de Lumea Justiției, Răzvan Savaliuc, a vorbit pe Aleph News și despre exodul magistraților din Justiție dar și performanța parchetelor în 2022:
„Din păcate, la avantaje a fost cea mai mare solidaritate la magistrați. Acum este într-adevăr un exod, o epurare. Acum li se spune: vă vom tăia pensiile. Magistrații se gândesc că mai bine ies acum la pensie, își păstrează banii, cam 5000 de euro pe lună. Intră în sistemul de justiție generațiile instruite pe la Bruxelles. Băieții care fac subiectele pentru intrare în INM au niște probleme la mansardă. N-o să mai vedem cazuri mari de corupție, DNA nu mai funcționează pentru dosare mari. DNA a fost înființată să epureze caza politică și mediul de afaceri. Noi am fost cuceriți ca stat de lupta anticorupție, nu mai avem resurse pe care să le exploatăm noi ca stat. Politicienii noștri sunt niște marionete.
Corupția va fi o temă ca să închizi gura celor care mai sunt voci libere în România. Cea mai mare corupție în România este evaziunea fiscală pe care o fac marile companii. Firmele românești sunt călcate în picioare. La firmele mari se duce cineva? Vezi DNA cu un dosar de corupție pe marile companii? DNA nu acționează unde trebuie. Bădălău n-a înțeles că nu se mai poate ca înainte”.
2023 este an de precampanie dar și anul unei posibile rocade în fruntea Guvernului între Nicolae Ciucă și Marcel Ciolacu. Răzvan Savaliuc este de părere că rocada între PNL și PSD nu se va întâmpla în 2023.
„Judecătoarea a scris că dosarul Ciucă pune în pericol stabilitatea României. Ciucă este omul care face ce vor cei de afară. Statul român are un președinte de paie, sub el sunt serviciile iar serviciile controlează politicul și justiția. Peste ei sunt cei de afară care pun serviciile la treabă. României nu mai are cum să-i fie bine. În Polonia se trăiește foarte bine, la fel și în Ungaria. Politicienii noștri de carton n-o să mai aibă forța să se opună poporului. La Schengen s-a văzut că începe românul să se trezească. Pe elementele care țin de identitatea și bunăstarea noastră, trebuie să te rupi de UE. Politicienii noștri au stat efectiv în patru labe, au dat tot și s-au trezit cu un duș rece. Bode să se ducă să învețe o limbă străină. Cum să intri în Schengen cu un ministru care nu știe o boabă de limbă străină? Categoric, partidele naționaliste vor fi pe creștere. Nu sunt împotriva UE, sunt împotriva mizeriilor care vin din UE. Da, în țara orbilor, chiorul este Împărat! Clasa politică n-are demnitate, n-are coloană vertebrală. Românii nu au pe cine să voteze. Dacă se ridică unul care nu este de al lor, este mitraliat de propagandă, de justiție și ong-uri (…) Nu cred că se va face rocada. PSD-ului i se va pregăti o nefăcută. Se va găsi o soluție minoritară tot cu PNL la guvernare. Aș vrea, dar nu cred că se va face vreo schimbare. Nu vor fi lăsați”, a declarat Savaliuc.
Jurnalistul crede că pentru eșecul aderării României la spațiul Schengen, de la finalul lui 2022, sunt de vină actualii guvernanți:
„Nu știu cât de reale sunt sondajele. Asta-i lupta: nu se atacă guvernarea, este atacată opoziția, vezi cazul AUR. Resursele statului sunt folosite să fie atacată Opoziția. Românul acceptă ușor și de frică tot. În toată lumea s-a condus prin frică. Marea masă a oamenilor nu se mai uită la tv, la media, pentru că nu mai vor știri negative. Este clar că este un comandament ca să nu se mai discute despre Justiție. Ei știu că suntem prea mici să schimbăm ceva, dar trebuie salvate și aparențele democrației. (…) Eșecul Schengen ar trebui să-l deconteze Președintele României. Proiectele lui Iohannis au fost România Educată și intrarea în Schengen. Bode, Ciucă și ministrul de externe – trebuie să deconteze eșecul Schengen. Ce-au căutat austriecii în vizită la Președinția României? Sunt obligați să ne spună! Nu cred că Austria a luat decizia de capul ei. Nu cred că se putea opune fără Germania. România este cea mai bogată țară din Europa la capitolul resurse naturale. PIB-ul Austriei este puțin mai mare decât cel al României. Dacă România le taie resursele, am avea un PIB mai mare decât al Austriei. (…) Cred că pe Klaus Iohannis îl vor umple de probleme. Sistemul trebuie să se perpetueze. Sistemul va veni cu altcineva care să-i ia locul lui Klaus Iohannis. Dacă sistemul vine cu soluții gen Ciucă, va fi vai de steaua noastră. Dacă-i iei foaia lui Ciucă din față, nu mai poate vorbi. Spre deosebire de Ciucă, Iohannis avea niște avantaje în plus. La PSD, dacă vor încerca să pună un lider în cursa pentru Președinția României, vor fi carotați din start. Dacă soluția Sistemului pentru Președinția României va fi Ciucă, înseamnă că ne ducem pe copcă. Sper ca stăpânii noștri de afară să fie mai umani, să ne lase să trăim. România din păcate n-are lideri iar serviciile nu par să lucreze pentru interesul național”.
The post Răzvan Savaliuc: „Dacă soluția Sistemului pentru Președinția României va fi Nicolae Ciucă, înseamnă că ne ducem pe copcă” appeared first on Aleph News.